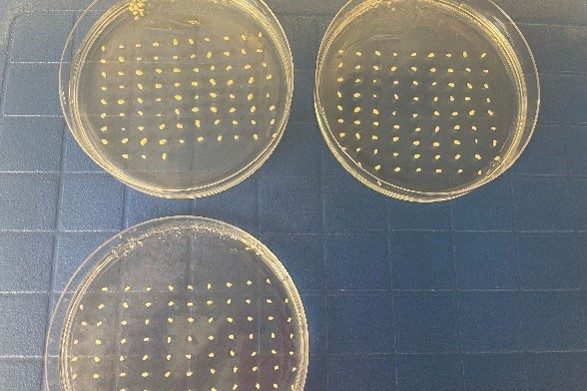

Maize Transformation
The Wisconsin Crop Innovation Center offers agrobacterium mediated maize transformation and gene editing services for the elite inbred LH244 variety released from PVP by Bayer. Our LH244 process targets immature embryos and follows a WCIC modified B104 protocol similar to (Raji, Jennifer A., et al. “Agrobacterium- and Biolistic-Mediated Transformation of Maize B104 Inbred.” Methods in Molecular Biology (Clifton, N.J.), vol. 1676, 2018, pp. 15-40)

Timeline of Maize Transformation
These systems generally take approximately 9-11 months from start to harvest of T1 seeds.
Bulked LH244 is also available for purchase in small quantities if needed for research or control use.

Additional Services and Crops
In addition to our standard Maize and Sorghum protocols, we are currently working to optimize our morphogenic regulator processes. We’ve licensed technologies from private companies to allow us flexibility in offering various techniques to perform these services for academic/non-profit as well as private entities.
We no longer routinely offer transformation services for Wheat, Brachypodium or Barley. If interested in further information, please contact Alvar Carlson.

Come Visit Us
The best way to learn about the College of Agricultural and Life Sciences is to visit our beautiful campus. We can’t wait to meet you and share all the reasons we love CALS!